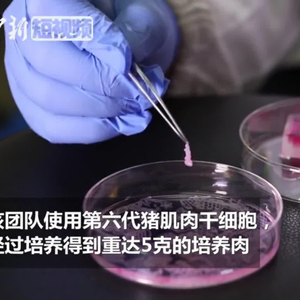

原标题:中国第一块“细胞培养肉”长这样
 中国第一块“细胞培养肉”长这样
中国第一块“细胞培养肉”长这样
11月22日,南京农业大学国家肉品质量安全控制工程技术研究中心公布,南京农业大学周光宏教授团队用动物干细胞生产研发出中国第一块肌肉干细胞培养肉,该团队使用第六代猪肌肉干细胞,经过前后20天的培养,得到重达5克的培养肉。
培养肉是指用动物肌肉干细胞培养、生产可食用的肉类,培养肉技术是肉类生产方式的一种变革性创新,是一种新的动物蛋白生产技术。培养肉的生产一般先通过活体采样获得动物的肌肉组织,再从组织中分离得到肌肉干细胞并在富含营养成分的营养液中大量培养成肌肉前体细胞,最后在可食用的三维支架材料中将肌肉前体细胞分化成熟为肌肉组织。
(画面由南京农业大学提供 记者 葛勇 江苏南京报道)